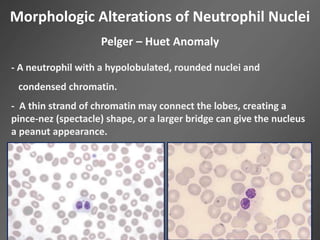
Morphologic Alterations of Neutrophil Nuclei
Pelger – Huet Anomaly
- A neutrophil with a hypolobulated, rounded nuclei and
condensed chromatin.
- A thin strand of chromatin may connect the lobes, creating a
pince-nez (spectacle) shape, or a larger bridge can give the nucleus
a peanut appearance.
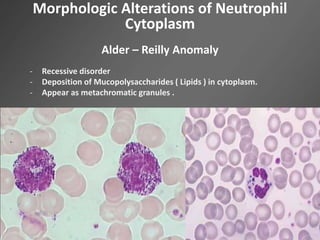
Morphologic Alterations of Neutrophil
Cytoplasm
Alder – Reilly Anomaly
- Recessive disorder
- Deposition of Mucopolysaccharides ( Lipids ) in cytoplasm.
- Appear as metachromatic granules .
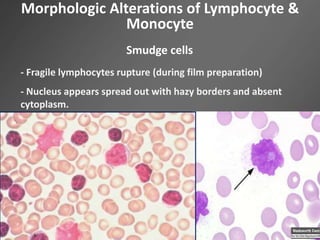
Morphologic Alterations of Lymphocyte &
Monocyte
Smudge cells
- Fragile lymphocytes rupture (during film preparation)
- Nucleus appears spread out with hazy borders and absent
cytoplasm.

Leukocytes, or white blood cells, are divided into myelocytes and lymphocytes. Myelocytes include granulocytes like neutrophils, eosinophils, and basophils, as well as monocytes. Lymphocytes include B and T lymphocytes. Leukopoiesis is the process by which these cells develop from hematopoietic stem cells in the bone marrow. Morphological abnormalities that can occur include alterations in neutrophil nuclei like the Pelger-Huet anomaly and cytoplasmic changes such as May-Hegglin anomaly. Lymphocytes and monocytes can also demonstrate abnormal morphologies like Reed-Sternberg cells.